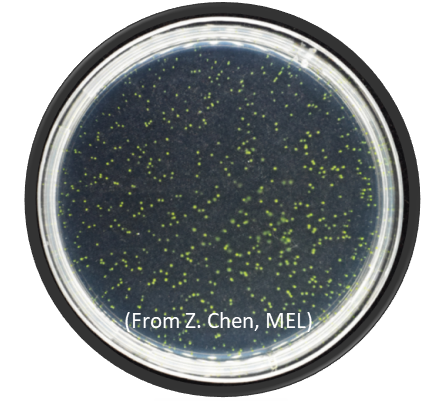
打破固有認知！廈大團隊耗時四年揭示原綠球藻的進化奧秘

大年初六,在短暫地與家人團聚後,廈門大學海洋與地球學院的博士生陳卓宇已經早早收拾好行囊,準備返校。
從2018年開始,他的每個春節幾乎都在實驗室度過,即便返鄉,時間也很短暫,因為他的心裡始終牽掛著廈園裡那些陪伴了他四年的“戰友”,他的實驗材料——原綠球藻。
當生態學遇上進化
早在幾億年前,原綠球藻就生活在地球上了,它的“祖先”更是早在約25億年前就開始進化,並在許多方面改變了地球。它們吸收並利用陽光中的能量,從水中分離出氧和氫,氧氣便開始在大氣中積累,給原本“缺氧”的地球帶來了繁榮的“大氧化”時代,為後續生物進化的高速發展提供了重要條件。
而今,作為海洋裡最重要的初級生產者,原綠球藻透過光合作用每年固定約40億噸碳,是“海洋碳匯”的重要貢獻者。
然而,如此重要的生物,卻因為太小,僅在三十多年前才被人類發現。
陳卓宇的導師,張瑤教授介紹道:“其實1毫升的大洋海水裡,就有多達10萬個原綠球藻。但因為它實在是太小了,從前落後的裝置和技術無法觀測到,人們才這麼晚認識到它。”
早在廈大讀博期間,張瑤就在導師焦念志院士的帶領下,邁入了“海洋微生物生態”研究領域的大門。畢業後留校任教的她,延續了多年的研究方向,潛心鑽研海洋生態學,原綠球藻就是她的主要研究物件之一。她知道,作為地球演化過程中極其重要的生物以及當今海洋裡最重要的初級生產者,原綠球藻具有無可替代的進化和生態學意義。
五年前,張瑤在一次與香港中文大學羅海偉教授的交談中,兩人一拍即合,迅速達成合作意向。“我是做生態的,他是做進化的,我們當時聊完就覺得,如果能一起把海洋裡如此重要的生物(原綠球藻)從‘進化生態學’的角度做清楚,那一定能做出相當重要的貢獻。”
於是研究正式啟動,當時剛剛從廈大本科畢業並留校讀博的陳卓宇便作為主力,開啟了長達四年的實驗。
“報告打得最多的人”
“培養原綠球藻”,看似簡單的第一步,成為了陳卓宇面臨的首道難題。
“原綠球藻非常難養,甚至早期學界都認為它‘不可培養’,經過多年的摸索,如今全世界也只有屈指可數的實驗室能把它成功養活,固體培養更是難上加難。”培養基所使用的海水、固體培養基的瓊脂糖濃度、培養時設定的光照強度和溫度……這些因素的細微變動都可能對原綠球藻的生長產生巨大影響。
在一次次嘗試中,陳卓宇不斷除錯實驗引數,並在香港科技大學曾慶璐教授的聯合指導下,最終成功克服了原綠球藻難以在實驗室培養的困難,摸索出了一套穩定的單克隆培養方案。
但很快,他又面臨著下一道難題——長時間地連續傳代。該研究的時長取決於原綠球藻在傳代中基因突變的數量,只有累積到一定的數量,才能進行有效的統計分析。然而,原綠球藻生長週期較長,而他們在實驗中又發現,原綠球藻基因突變的速率很慢,這在顛覆了學界認知的同時,也使得實驗的時長跨越了四年之久。
四年裡,陳卓宇成為了學院裡“報告打得最多的人”。受疫情影響,近年我校嚴格校園管理。在校園和實驗室短期嚴管人員流動時,陳卓宇一次次提出返校、進入實驗室的申請,作為導師的張瑤則一次次地幫他簽字、提交申請。
累積培養1065天,連續傳代39次,最終存活141個細胞系……實驗就在這一次次的“申請報告”中順利完成了。
“科學是在不斷修正中發展的”
原綠球藻數量龐大、分佈廣泛。而“遺傳漂變”是種群基因庫在代際發生隨機改變的一種過程,通常在小群體裡尤為明顯。多年來,學界一直預設原綠球藻有效種群規模很大,進而認為自然選擇在原綠球藻進化適應過程中極其有效,忽略了遺傳漂變的作用。
然而,該研究計算出原綠球藻的有效種群規模僅為1.68 × 107,小於許多典型的海洋自由生活菌;進一步分析發現,原綠球藻雖分佈廣泛,但不同的小生境被不同代謝特點的孤立種群所佔據。“就像是生活在不同地區的人群,適應其所在的環境,擁有不同的特徵。”但同時各種群之間彼此孤立,不發生基因交流,種群內部基因重組水平較低。
因此,研究提出了“週期性選擇”的原綠球藻遺傳漂變加強機制,給寡營養海域中優勢菌群常見的基因縮減現象,在傳統的“寡營養環境適應”觀點之外,提供了一種創新的觀點和理論。
該研究證明,在原綠球藻進化過程中,人們所熟知的“自然選擇”並不如傳統認知的那麼重要,而一直被忽略的“遺傳漂變”發揮著關鍵作用。

△ 論文配圖:核生物基因組大小(G)、鹼基替換速率(μ)、全基因組突變速率(Up)、有效種群數量(Ne)之間的相互關係
“這個世界上有這麼多的物種,它們並不一定都是自然選擇選出的佼佼者,有些物種它可能只是幸運地存活了下來而已。雖然大眾已經普遍理解並篤信了‘自然選擇’的作用,但我們不能因此就忽視了‘遺傳漂變’的作用。”該研究的一系列發現,打破了學界對原綠球藻進化的固有認知。
張瑤說:“我們獲得的實驗結果,有的符合已有的理論,有的不符合。這是因為理論並非真理,它始終處在動態發展的過程中,需要我們不斷地驗證、修正它。科學就是這樣,就是在不斷修正中發展的。”
近日,該研究以“Prochlorococcus have low global mutation rate and small effective population size”為題在國際頂級期刊 Nature Ecology & Evolution(《自然·生態與進化》)上刊發。陳卓宇和香港中文大學王曉君博士為論文共同第一作者,張瑤教授和香港中文大學羅海偉教授為論文共同通訊作者。
苦心耕耘的實驗雖已結出碩果,但研究還將延續。“我們會繼續堅持這141個細胞系的傳代工作,未來計劃圍繞‘全球變化’領域拓展研究。”在他們心中,科學沒有終點,探索也將永不止步。
來源:廈門大學